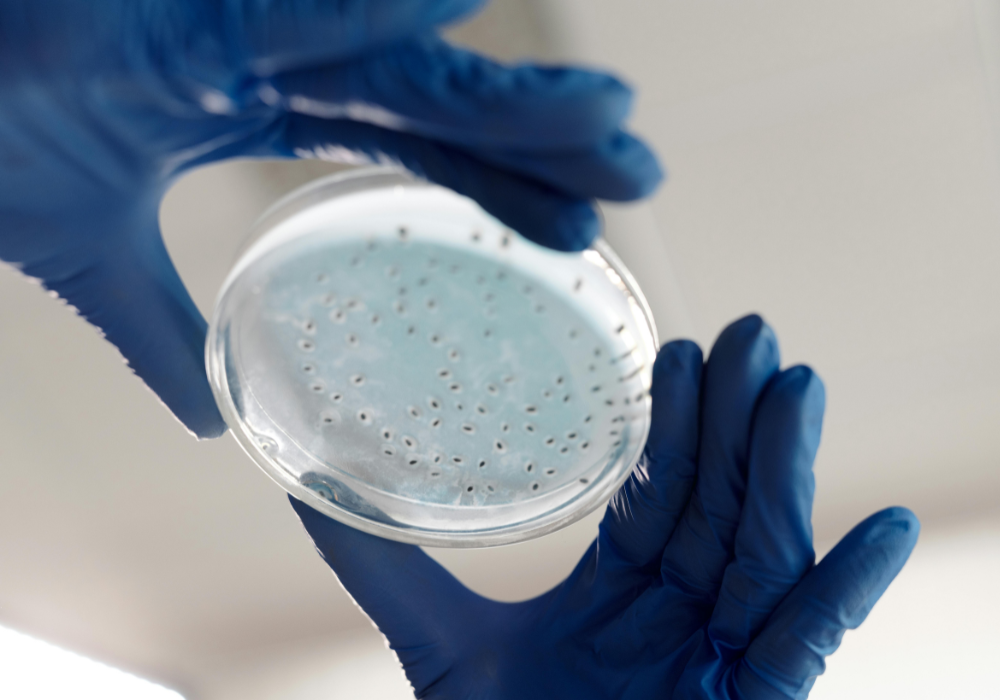

New research shows coral’s microscopic partners could boost reef resilience against rising ocean temperatures.

Coral reefs may have a secret weapon against climate change—and it’s so small you can’t see it with the naked eye. New research from the Smithsonian Tropical Research Institute found that the microscopic organisms living inside corals, known as microbiomes, could help them survive in hotter oceans.
Scientists compared corals from two regions of Panama: one with regular bursts of cooler, nutrient-rich water and one with steady, warmer seas. The heat-hardened corals fared far better in lab tests, and researchers believe their microbiomes played a big role—offering fresh hope for reefs in a warming world.
1. Microbial “Bodyguards” Are Giving Corals a Heat Shield
In recent experiments, researchers observed that corals hosting specific microbiome communities were significantly more resistant to bleaching under heat stress. These microbes appear to regulate internal coral chemistry, boosting antioxidant activity and repairing cell damage more efficiently. According to the study, the difference in bleaching severity between corals with and without these microbes was dramatic.
This suggests that some microbiomes act almost like a natural sunscreen—helping corals maintain their energy production even in overheated waters. If scientists can find ways to introduce these microbial bodyguards into vulnerable coral species, they might be able to create heat-hardened reefs capable of surviving more frequent marine heat waves.
2. Heat-Resistant Microbes Could Be Transplanted Into Weaker Corals

Marine biologists have identified coral species whose microbiomes naturally include heat-tolerant microbes capable of functioning in warmer waters without shutting down. In controlled trials, these microbes were transplanted into more sensitive coral species, and the results were promising—bleaching severity dropped, and survival rates increased.
This approach, sometimes called “microbiome engineering,” could one day be used in coral nurseries before young colonies are planted back into the reef. While it’s not a permanent solution to climate change, it offers a practical, near-term way to fortify corals ahead of seasonal heat spikes, potentially reducing the massive die-offs we’ve seen during recent ocean heat waves.
3. Microbiomes Help Corals Bounce Back After Bleaching

When bleaching occurs, corals lose the symbiotic algae that provide most of their energy, leaving them stressed and vulnerable. Recovery depends on how quickly they can rebuild that partnership. Certain microbiomes appear to accelerate this process by enhancing nutrient cycling and reducing inflammation within coral tissue.
These beneficial microbes also help restore the coral’s energy reserves faster, giving them a better shot at surviving long enough for algae to return. In reefs where heat stress is seasonal, this faster recovery could mean the difference between a coral dying in one bad summer or surviving to face another, giving restoration efforts more time to work.
4. Some Microbes Protect Corals From Deadly Diseases

Disease outbreaks have become a growing problem for coral reefs, often striking after heat stress weakens the animals. Researchers have found that certain microbiomes contain bacteria that can inhibit or outcompete pathogens, essentially acting as a natural immune system. In lab tests, corals with these protective microbiomes suffered fewer infections even when exposed to high disease pressure.
This dual benefit—resisting both heat stress and disease—could make these microbial communities especially valuable for reef conservation. If these protective microbes can be encouraged in the wild, they might help curb the devastating losses from coral diseases now seen in many tropical regions.
5. Microbiomes Improve Coral Nutrition in Lean Waters

Not all reef environments are nutrient-rich, and in nutrient-poor waters, corals rely heavily on their microbiomes to help break down food sources. Some microbes can process compounds that corals themselves cannot digest, converting them into usable nutrients. This extra nutritional boost is especially important after bleaching events, when corals are low on energy and struggling to rebuild.
Enhanced nutrition from microbiomes may help corals survive longer periods of stress without losing too much tissue mass. In a rapidly changing ocean, these nutrient-processing microbes could be a key factor in determining which corals persist and which disappear from vulnerable reef ecosystems.
6. Pollution-Stressed Corals May Benefit From Microbial Detox

Coastal reefs near human populations often face additional stress from pollution, such as agricultural runoff, sewage, and industrial waste. Some coral microbiomes contain microbes that can break down or neutralize these contaminants, reducing their harmful effects. In studies, corals with these detoxifying microbes maintained healthier tissue and suffered less bleaching in polluted waters compared to those without them.
While this doesn’t make reefs immune to pollution, it suggests that boosting these microbial communities could help corals cope with multiple stressors at once—a critical advantage in places where climate change and human impacts intersect.
7. Warming Seas Are Changing Microbial Communities—For Better or Worse

As ocean temperatures rise, the makeup of coral microbiomes naturally shifts. In some cases, more heat-tolerant microbes move in, improving coral resilience. In others, beneficial microbes disappear, leaving corals more vulnerable to stress and disease. Understanding these shifts is a major research focus, as scientists hope to identify the conditions that encourage “good” microbial changes while discouraging harmful ones.
By learning to manage these shifts, conservationists might be able to guide microbiome evolution in a way that helps corals adapt more quickly to the reality of warmer, more unpredictable oceans.
8. Coral Nurseries Are Experimenting With Microbiome Boosting

Some restoration projects are already testing the idea of enhancing coral microbiomes in nurseries before planting them in the wild. Young corals can be exposed to beneficial microbes early, giving them a built-in advantage when they face heat stress or disease later.
This “probiotic” approach is still experimental, but early results are promising—nursery-raised corals with enhanced microbiomes are showing higher survival rates once transplanted. If scaled up, this could become a standard step in reef restoration, making the corals we plant today more likely to thrive in tomorrow’s harsher ocean conditions.
9. Microbial Diversity Seems Tied to Coral Longevity

Research suggests that corals with a more diverse microbiome are better at coping with stress over time. Diversity provides functional redundancy—if one group of microbes is lost, others can often take over its role. This stability helps corals maintain their health even as environmental conditions fluctuate.
Efforts to preserve or restore microbiome diversity could therefore be as important as protecting the corals themselves. In practical terms, it means that reef conservation may need to focus on maintaining not just the visible coral structures, but also the invisible microscopic ecosystems that keep them alive.
10. Breeding Climate-Ready Corals With Microbiome Selection

Selective breeding programs have been used to improve coral traits like heat tolerance, but now some scientists are factoring microbiomes into the process. By breeding corals that naturally host strong, heat-tolerant microbial communities, researchers hope to pass these advantages to future generations.
This could result in corals that are not only genetically resilient but also equipped with microbial allies from birth. While it’s a long-term strategy, it aligns with the urgent need to prepare corals for the hotter, more stressful oceans expected in the coming decades.
11. Saving Corals Means Saving Their Microscopic Partners

Conservation efforts often focus on protecting the corals themselves, but this research makes it clear that their microbiomes are just as vital. Without the right microbial communities, even the healthiest-looking coral may be unable to survive prolonged stress.
Protecting these invisible partners means safeguarding water quality, minimizing pollution, and supporting conditions that allow beneficial microbes to flourish. As climate change accelerates, the future of coral reefs may depend on our ability to preserve and even enhance the microscopic life that keeps them thriving.